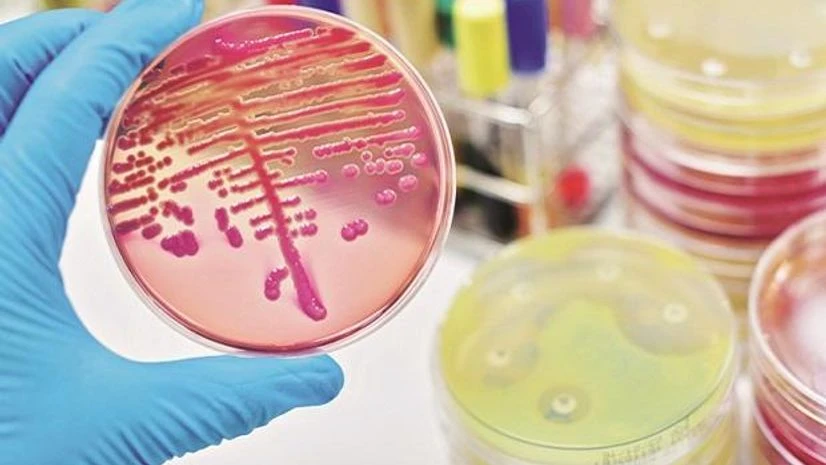
pharma pharma

Shares of pharmaceutical companies rallied on Tuesday with the Nifty Pharma index surging 10 per cent as the government lifted the curbs on exports of 13 active pharmaceutical ingredients (APIs) and their formulations. The index had rallied 5 per cent in the previous session also.
The ban on export of hydroxychloroquine (HCQ) -- claimed to be effective to treat coronavirus (COVID-19) -- may also be lifted, Business Standard said in a report.
At 11:37 am, Nifty Pharma -- the top gainer among sectoral indices -- was up 10 per cent at 8,095, as compared to 5.2 per cent
The ban on export of hydroxychloroquine (HCQ) -- claimed to be effective to treat coronavirus (COVID-19) -- may also be lifted, Business Standard said in a report.
At 11:37 am, Nifty Pharma -- the top gainer among sectoral indices -- was up 10 per cent at 8,095, as compared to 5.2 per cent
)